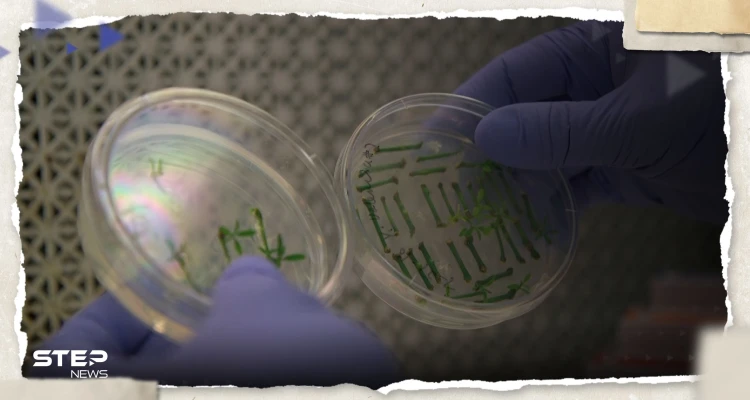

أعلن فريق من الباحثين في الولايات المتحدة والمملكة المتحدة أنهم نجحوا في إنشاء أول هياكل اصطناعية شبيهة بالأجنة البشرية (نموذج) من دون بويضات أو حيوانات منوية، في اختراق علمي قد يثير جدلا أخلاقيا وقانونيا.
وعلى الرغم من الهياكل لا تزال في المراحل الأولى من التطور البشري، إلا أنّ العلماء يقولون إن هذه الأجنة النموذجية تُشبه تلك التي كانت في المراحل الأولى من التطور البشري، حيث تتمتع بقلب نابض، أو دماغ.ويرى العلماء أن التجربة قد تُساهم يوما ما في تعزيز فهم الأمراض الوراثية، أو الأسباب البيولوجية المؤدية للإجهاض المتكرر.وأثار هذا البحث الكثير من الأسئلة الأخلاقية والقانونية المهمة، خاصةً وأن العديد من الدول وعلى رأسها الولايات المتحدة الأمريكية، لا تتمتع بقوانين خاصة بتنظيم إنشاء أو معالجة الأجنة الاصطناعية.وتُعد هذه التجربة اختراقا علميا، حيث كان يتعين على العلماء الالتزام بقاعدة الـ14 يوما التي تدل على أنهم كانوا مقتصرين على السماح للأجنة بالنمو في المختبر لمدة أقصاها أسبوعان.وعقب هذا الاختراق، سيتعين على العلماء الانتظار فترة أطول على امتداد تطورها لاستكمال دراستهم، معتمدين في ذلك على فحوصات الحمل والأجنة.وتحدثت الدكتورة ماجدالينا زرنيكا، أستاذة علم الأحياء والهندسة البيولوجية في معهد "كاليفورنيا" للتكنولوجيا، عن الدراسة في عرض تقديمي الأربعاء، وأشارت إلى أن البحث تم قبوله في مجلة علمية مرموقة ولكن لم يتم نشره بعد.وأفادت الأستاذة ماجدالينا: "يمكننا إنشاء نماذج شبيهة بالأجنة البشرية عن طريق إعادة برمجة الخلايا الجذعية الجنينية".وذكرت زرنيكا-جويتز أنه على حد علمها، هذه هي المرة الأولى التي يتم فيها تكوين نموذج لجنين بشري يتمتع بثلاث طبقات من الأنسجة.كما أكدت الباحثة، أن الهدف من التجربة ليس خلق الحياة، بل منع فقدانها، وفهم سبب فشل الأجنة في النمو بعد عملية الإخصاب، والزرع.اقرأ أيضاً.. تعرف على 7 أسباب لآلام الجانب الأيمن من البطن ومتى يكون خطير؟Steve Bannon & Joe Allen: Scientists Create Synthetic Human Embryos - 6/14/23 pic.twitter.com/A4HH0XxQgz
— DOWNLOAD.NEWS - AlexJonesMinerV2 (@DOWNLOADdotNEWS) June 15, 2023